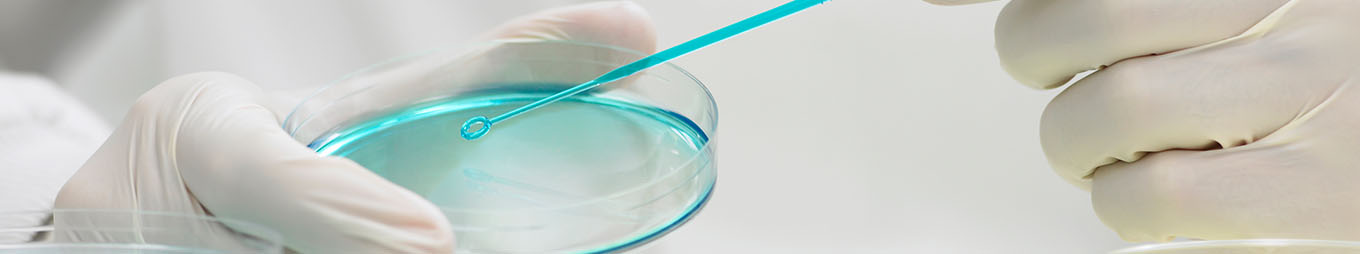

Credit
Credit FAQ: Bausch Health Companies Inc.: What’s The Credit Quality Following Spinoff Of Eye-Care Unit?
Bausch Health Companies Inc. recently announced its intention to spin off its eye-care business. The remaining entity (RemainCo) will focus on gastroenterology, aesthetics/dermatology, neurology, and international pharmaceuticals.
In this Credit FAQ, S&P Global Ratings answer investors' questions about RemainCo's business profile.
Credit FAQ: Medical Devices And Life Sciences: Improving Vitals, Ratings Remain In Guarded Condition
The COVID-19 pandemic has disrupted health care systems operations across the globe, with no precedent to look back on. While we normally think of medical devices as among the most stable of health care subsectors, there was a disproportionate negative impact to medical device companies from the March halt in elective procedures across the globe.
Read the Full ArticleSBPA-Backed VRDOs
Checkup On Not-For-Profit Health Care SBPA-Backed VRDOs in the COVID-19 Era
S&P Global Ratings currently rates 904 primary market variable-rate demand obligations (VRDOs) that are backed by standby bond purchase agreement (SBPA) obligations with a par total of approximately $69.8 billion. VRDOs are bonds with interest rates that reset periodically and may include a bondholder put option. The U.S. public finance (not-for-profit) acute health care sector currently has 86 SBPA obligations that represent about 10% (approximately $7 billion) of all SBPAs.
Key Takeaways
- The U.S. public finance health care sector currently accounts for about $7 billion or 10% of the $69.8 billion VRDOs backed by SBPAs that we rate.
- Our sector outlooks for all public finance sectors are now negative, and, as of July 31, we had negative rating outlooks on 26% of the stand-alone not-for-profit health care providers and 17% of the not-for-profit health care systems we rate.
- Not-for-profit health care providers in the 'AA' rating category continue to have access to the SBPA market, though pricing has increased somewhat and tenors have shortened.
- Although unlikely, remarketing failures and draws on SBPA providers could increase if bondholders elect to tender their bonds due to impact of the pandemic and investors' concerns about obligors' overall credit quality and the potential loss of put options if SBPAs terminate without notice.
At S&P Global Ratings we are continuously assessing the economic and credit impact of the COVID-19 pandemic around the world. Subscribe to our Coronavirus Bulletin today and we will ensure you have all our latest research and forecasts as they are published.
Subscribe to the NewsletterPressure on Pharma
How Business Strength Varies Across the Top Pharma Companies
The top branded pharmaceutical companies have strong investment-grade ratings based on an attractive and highly profitable business model, combined with conservative levels of adjusted net debt leverage and strong cash flow generation.
What Does Pharma’s Quest for a COVID-19 Vaccine Mean for its Credit Quality and ESG Profile?
The COVID-19 pandemic has placed much of the hope of returning back to normal on the pharmaceutical industry to develop effective treatments and vaccines. In S&P Global Ratings' opinion, innovation is the key to sustaining a successful pharmaceutical company.
Read the full articleExecutive Orders on Drug Pricing will have Limited Effect but Underscore the Continued Pressure on the Pharmaceutical Industry
President Trump announced last Friday that he is planning to sign four executive orders aimed at lowering pharmaceutical prices. However, S&P Ratings views the likelihood that any of these proposals will be implemented in the near term as low.
Read the Full Article
Telehealth Boom
Chronic Care, Mental Health May Be M&A Targets In Telemedicine 'Arms Race'
Teladoc Health Inc.'s $18.5 billion acquisition of digital chronic care management provider Livongo Health Inc. — the largest healthcare deal of the year — has analysts wondering who could be next as the COVID-19 pandemic pushes more patients online.

Digital Health Player Biofourmis Secures $100M Investment led by Softbank
Biofourmis Inc., a privately held digital therapeutics company based in Boston, has completed a $100 million Series C funding round led by SoftBank Corp.
The round also included funding from existing investors EDB Investments Pte. Ltd., MassMutual Ventures LLC, Openspace Ventures Pte. Ltd. and Sequoia Capital Operations LLC.
Read the Full ArticleStay up to date with the latest news and insight from S&P Global Market Intelligence on public health, the global economy, its sectors, and commodity markets. This newsletter will be sent every Thursday.
SUBSCRIBE TO THE NEWSLETTERVaccine Race
First In Human: In Race Against COVID-19, Early-Stage Vaccine 'Noise' Pervades
The acceleration of clinical trials for COVID-19 vaccine candidates has raised concerns that conclusions will be difficult to draw from study results, particularly as early-stage research blends into larger-scale trials, experts say.

COVID-19 Vaccine Trust, Scalability Are Front Of Mind At HLTH Conference
As pharmaceutical companies edge closer to an effective coronavirus vaccine, healthcare executives say building trust with the public is the next hurdle in combating the pandemic.
Read the Full ArticleAstraZeneca, COVID-19 Vaccine Contenders Keep One Eye on Future Pandemics
With established manufacturers and new entrants racing to complete clinical trials of their experimental coronavirus vaccines in record time, some are already looking beyond their new-found COVID-19 expertise to better prepare for future pandemics.
Read the Full Article
Supply & Insurance
Octopus Tentacles as Surgical Tools; Spider Web Imaging; Antibiotic Wasp Venom
Researchers at the University of Illinois have turned to an unlikely source to create material used in surgery and wound healing: the suckers that line the tentacles of an octopus.
The group of scientists took inspiration from the octopus's ability to pick up various materials using small pressure changes in the suction cups on its tentacles. The same method can be used to create sheets of cells or electronics that can aid in wound healing, regenerative medicine and biosensing.
Molina CEO Saw 18% Jump in '19 Pay; 6 Health Insurer Execs Earned More Than $15M
The top executives at seven publicly traded managed care insurers in the U.S. all saw their total compensation for 2019 rise on a yearly basis, with six of them earning more than $15 million each.
Joseph Zubretsky of Molina Healthcare Inc. was paid $18.0 million in total adjusted compensation, an 18.4% rise compared to 2018. He received $13.0 million in stock awards last year.
Anthem Inc. CEO Gail Boudreaux earned $15.5 million, up 9.1% compared to her annualized pay in 2018, with $8.4 million of that total coming from stock grants and $2.8 million in options.
Read the Full Article
M&A Activity
Chronic Care, Mental Health May be M&A Targets in Telemedicine 'Arms Race'
Teladoc Health Inc.'s $18.5 billion acquisition of digital chronic care management provider Livongo Health Inc. — the largest healthcare deal of the year — has analysts wondering who could be next as the COVID-19 pandemic pushes more patients online.
Telemedicine companies that may be looking to conduct acquisitions include Amwell, which recently filed for an IPO; MDLIVE Inc.; and Doctor on Demand Inc. RBC Capital analyst Sean Dodge said these companies are likely looking for ways they can become all-in-one platforms instead of singular point solutions.
Bristol-Myers $13.1B deal shows industry's hunger for M&A in H2'20
Bristol-Myers Squibb Co.'s intent to purchase heart-drug maker MyoKardia Inc. for $13.1 billion marks the fourth healthcare M&A deal of 2020 valued over $10 billion and the most recent in a string of acquisitions announced in the second half of the year.
Of the sector's 17 deals with a transaction value above $1 billion, 13 have been announced in the second half of 2020, and only one — Gilead Sciences Inc.'s purchase of Forty Seven Inc. — was announced before May.
Financial Health
Biotechnology Draws $12.6B from Private Equity, Venture Capital Activity in H1
Biotechnology led the healthcare industry in investment activity from private equity and venture capital during the first half of 2020, drawing nearly $12.60 billion in funding, up from $7.28 billion for the year-ago period.
The biotechnology sector either announced or concluded 342 deals globally as of June 30, comprising mergers and acquisitions and private placements, where the main investor was either a venture capitalist, a hedge fund manager or a private equity company, according to an analysis by S&P Global Market Intelligence.
Royalty Pharma IPO Pushes Funds Raised in Healthcare Debuts Past $10B in Q2
Royalty Pharma PLC 's $2.01 billion IPO led a pack of healthcare companies joining the public market in the second quarter of 2020 that raised $10.45 billion — the most for the quarter in the past five years, according to data compiled by S&P Global Market Intelligence.
The proceeds from IPOs for the sector are the highest in a five-year period starting from 2015, largely as a result of Royalty Pharma's contribution as the biggest U.S. IPO for the year so far.
The quarter saw 54 healthcare companies go public globally — with most of them based in China — raising the total number of IPOs completed in the sector to 90 as of June 30.
Read the Full Article
Social Factors
Treating the Cause, Not the Symptoms: How Societal Factors are Starting to Shape U.S. Health Care
Social determinants of health (SDOH) are the conditions under which people live and work that affect their health and health risks. They are increasingly reshaping how the U.S. provides and pays for health care. Indeed, both the private and public sectors are recognizing that SDOH will help society achieve a better relationship between health care costs and quality.
Over the past couple of decades, the U.S.'s attempts to provide quality health care to its population and control costs--broadly referred to as health care reform--have had very mixed results. However, the recognition of SDOH has brought a new and broader meaning to health care reform, given the transformational trends in care delivery and payment methodologies. This requires companies to revise their growth strategies, including new ways of investing capital. Given that S&P Global Ratings credit analysis continues to incorporate these factors, we believe SDOH will increasingly influence credit ratings.
Capitol Hill Seeks To Grill U.S. FDA, CDC Chiefs about COVID-19 Political Pressure
House and Senate lawmakers want U.S. Food and Drug Administration Commissioner Stephen Hahn to testify about whether his agency is being politically pressured to quickly approve a COVID-19 vaccine and other products before they have demonstrated safety and efficacy.
Read the Full ArticleThe Health Care Credit Beat: Governor Abbott Orders Elective Procedures Postponed
In late June, as coronavirus cases rose sharply in the state, Texas governor Greg Abbott ordered hospitals in eight counties to postpone elective surgeries and procedures that are not immediately medically necessary, to ensure beds are available for COVID-19 patients.
Read the Full Article
Sector Review
U.S. Not-For-Profit Acute Health Care Mid-Year Sector View: Recovery Continues, Likely Uneven for the Rest of the Year
While the deep wounds from the loss of revenues related to the government shutdown of non-essential and non-emergent care may be in the rearview mirror, we believe acute-care hospitals and systems will continue to experience an uneven financial recovery into 2021.
Our sector view S&P Ratings' continues to be negative as hospitals try to climb back to pre-COVID-19 volumes and margins. Hospitals in most regions are ramping up non-emergent and elective procedures and services, and we don't believe we will see a repeat of the widespread and extreme revenue and margin declines experienced in March and April.
Industry Top Trends Mid-Year 2020 Update: North American Health Care
The collapse in patient volumes, due in part to directives to conserve hospital capacity and patient fears, highlighted the discretionary component of health care and the uncertainty on pace of recovery.


